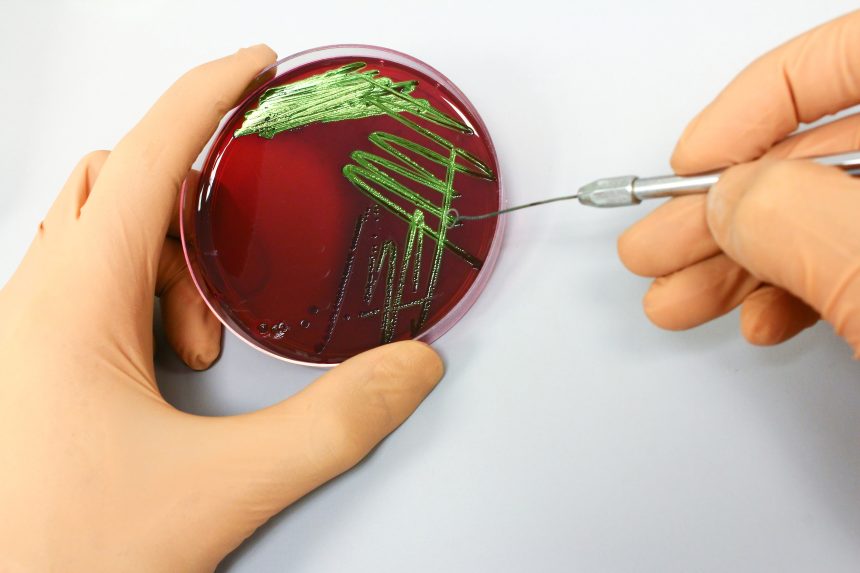
Culturing on an agar plate.

Contents:
- What content is covered in A Level Biology?
- How is A Level Biology assessed?
- Is A Level Biology hard?
- What grades do you need to do A Level Biology?
- What skills will you develop when studying A Level Biology?
- Where can A Level Biology lead you?
- What subjects go well with A Level Biology?
- Do you need to study A Level Maths alongside A Level Biology?
What content is covered in A Level Biology?
A Level Biology explores the intricacies of living things.
The course covers core topics such as biological molecules, cell structure and function, genetics, evolution, and ecosystems. Students will delve into the mechanisms of life, including energy transfers in and between organisms and the response of organisms to changes in their environments. You will develop existing GCSE knowledge and have the opportunity to learn about brand-new topics.
You will be prompted to engage in thoughtful conversation and to discuss the ethical and practical implications of technologies like genetic engineering and genetic cloning. You will also learn to use the scientific method, plan and conduct experiments, and evaluate experimental design.
How is A Level Biology assessed?
If you take Biology A Level, you can expect to sit 3× written exams:
- 2× exams assessing module-specific content. These are made up of multiple choice, structured questions, and extended response questions.
- 1× exam assessing content and skills across the entire course. This is made up of structured and extended response questions only.
Additionally, you will complete a series of laboratory practicals that relate to the theoretical content of the course and cover a range of experimental techniques.
These practicals contribute to the achievement of a Practical Endorsement in biology. Whilst this doesn’t count towards your grade, it is a requirement for most undergraduate science courses.
Is A Level Biology hard?
A Level Biology can be challenging, but rewarding.
The concepts are generally straightforward to grasp and there is an abundance of online resources available to aid students in their studies. For example, you can find tonnes of A Level Biology revision notes, summary sheets, and topic-specific questions on Physics and Maths Tutor. YouTube also offers a treasure trove of educational videos for students looking to grasp more complex concepts.
Many students find A Level Biology particularly content-heavy. The large volume of information that you will be expected to understand and memorise can feel overwhelming. However, with a consistent study routine and effective time management, there is no reason why you shouldn’t be able to succeed.

What grades do you need to do A Level Biology?
Most sixth forms and colleges typically require students to have achieved at least a grade 4 in GCSE Biology (or double science), English and Maths.
Since basic GCSE Maths skills constitute roughly 10% of the A Level Biology curriculum, it’s crucial to feel confident in your mathematical abilities. You’ll need to be comfortable working with data presented in tables and graphs, performing calculations, and using statistical tests. Moreover, having a solid grasp of GCSE Chemistry concepts is essential, as many biology topics overlap with elements of chemistry.
What skills will you develop when studying A Level Biology?
Studying A Level Biology will help you develop a wide range of transferable skills important for academic and career growth in the biological sciences and beyond.
As you encounter new biological concepts and challenges, you will improve your problem-solving abilities. You’ll become well-versed in the scientific method, learning how to formulate hypotheses, design experiments, and draw meaningful conclusions from real data. Studying A Level Biology will also help you become proficient in data analysis, a skill vital not just in scientific research but also in areas like statistics and data-driven decision-making.
Top tips for studying A Level Biology
- Break it down – Biology is a content-heavy subject. Try not to get overwhelmed by the amount of information you need to learn. Instead, focus on each topic and find keystones (prompt words or facts that will trigger your memory). Build associations this way, and the content won’t feel so large and intimidating.
- Quiz your friends – Teaching someone else is the best way to learn. Get some friends together and take turns acting as the teacher and the pupil. One person can ask the questions using flashcards, and the other can try to recall the answers from memory.
- Determine what you need to memorise – Know which formulae and equations you’re expected to remember so you can streamline your revision accordingly. There’s no point memorising things you’ll be provided in the exam.
- Look at the specification – This is a list of all content that may come up in the exam. When revising, consult this regularly to track your progress.
Where can A Level Biology lead you?
A Level Biology is a common requirement for Medicine and Healthcare, Psychology, Sports and Fitness, and Natural Science (including Biology, Biomedical Science, and Biochemistry) courses at university.
A Level Biology can lead to careers opportunities in:
- Agriculture
- Cell biology
- Ecology
- Environmental science
- Forensic science
- Human sciences
- Life sciences
- Marine biology
You might opt to study one of these specialisms in higher education, or you could keep your options open by studying a broader ‘Biology’ degree.

What subjects go well with A Level Biology?
Biology, chemistry, and maths is the most popular combination of A Level subjects, since it keeps various academic and career pathways open. This trio of subjects not only equips students with essential scientific knowledge, but also enhances their problem-solving and analytical thinking – skills valuable in many fields.
Biology also pairs well with subjects like psychology and geography.
Psychology delves into the intricate workings of the human mind and behaviour, and when paired with biology, opens doors to careers in healthcare, counselling, or research.
Combining biology with geography allows students to explore the relationships between living organisms and their environments, paving the way for careers in environmental science, conservation, or geospatial analysis.
Do you need to study A Level Maths alongside A Level Biology?
Whether you should study A Level Maths alongside A Level Biology will depend on your interests and career aspirations. If you’re hoping to study biology (or a related course) at university, you’ll need to take a second Science or Maths A Level.
Taking maths can provide valuable support for A Level Biology. Mathematics helps you understand and apply statistical concepts, which are crucial in biology for interpreting experimental data and drawing meaningful conclusions. It will also aid in understanding of probabilities in genetics, rates of change, and modelling biological systems.
Combining mathematics and biology prepares you for interdisciplinary work, which is common in scientific research and healthcare fields.
There are alternatives to A Level Maths that can support you with any maths that crops up in your studies. For example, you could take AS Level Maths or study for a Free Standing Maths Qualification (FSMQ).


Comments